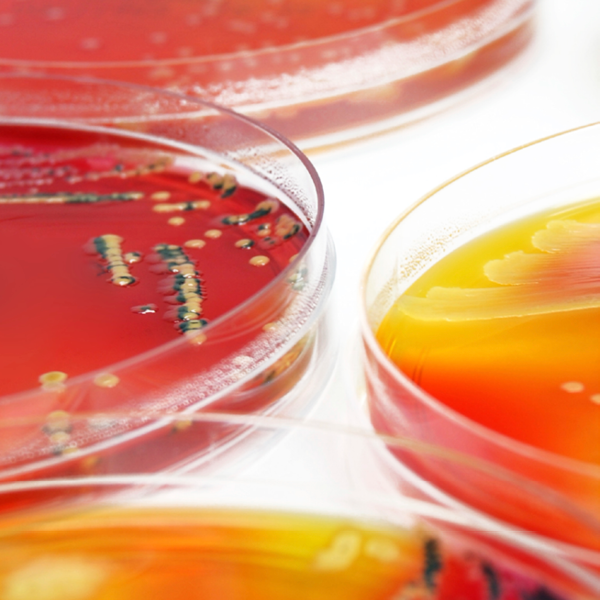
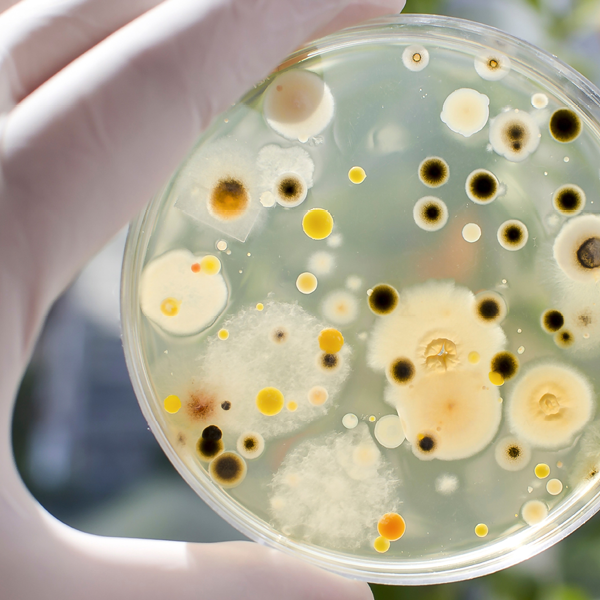

Løft kompetansen med skreddersydde kurs for trygg matproduksjon
Ønsker dere å styrke mattryggheten og fagkompetansen internt? Våre bedriftsinterne kurs gir dere akkurat det – vi leverer skreddersydd opplæring, og vi kommer til dere!
Våre kurs kombinerer faglig tyngde med praktisk relevans, og kan tilpasses deres behov – enten dere ønsker et spesifikt tema eller en helhetlig opplæringspakke. Vi kommer til dere og sørger for at innholdet er relevant for deres produksjon, rutiner og utfordringer. Tilbakemeldingene er svært gode – deltakerne opplever kursene som relevante, engasjerende og direkte nyttige i arbeidshverdagen.
Fordelene for din bedrift:
- Skreddersydd innhold tilpasset deres produksjon og utfordringer
- Ingen reise – vi kommer til dere!
- Vi tilbyr fysiske, digitale eller hybride kurs
- Engasjerende foredragsholdere
- Praktisk og faglig oppdatert undervisning
- Mulighet for både standard og spesialtilpassede kurs
Kontakt
Ta kontakt med oss i dag for en uforpliktende prat om hvordan vi kan bidra til å styrke kompetansen i din bedrift. Sammen skaper vi en tryggere og mer effektiv matproduksjon!
Food Consulting
Mattrygghetskonsulenter
Tel: 480 66 771
foodconsulting@ftn.eurofins.com
Eksempler bedriftsinterne kurs avholdt hos kunde:
HACCP
Lær hvordan du sikrer trygg mat i din bedrift!
Kurset gir virksomheten en grundig forståelse av HACCP-prinsippene og praktiske verktøy for å implementere dem i arbeidshverdagen. Vi tar utgangspunkt i virksomhetens egen drift og jobber sammen med deltakerne for å sikre at prinsippene settes ut i praksis. Innholdet er i samsvar med kravene i regelverket og Codex Alimentarius. Etter gjennomført kurs vil deltakerne være viktige bidragsytere til å styrke mattryggheten i bedriften.
Trygg mat og hygiene
Praktisk kunnskap for daglig drift
Kurset setter søkelys på hvordan virksomheten kan bygge en sterk matkultur. Vi går gjennom virksomhetens egne rutiner og gir deltakerne kunnskap om hygiene, HACCP og effektiv avvikshåndtering. Gjennom dialog og praktiske eksempler ser vi på hvordan dagens praksis kan forbedres, slik at hele virksomheten jobber mot målet om trygg mat.
Sensorikk
Forstå og forbedre smak, lukt og kvalitet
Gjennom dette kurset tilbys en unik mulighet til å øke deltagernes sensoriske kunnskap. Vi utforsker de fem grunnsmakene og hvordan alle sansene påvirker smaksopplevelsen. Gjennom praktiske øvelser vil deltagerne lære å bruke sensorikk for å utvikle og forbedre produktkvalitet
Regelverk
Oversikt og forståelse av gjeldende krav
Kurset gir en praktisk innføring i de viktigste forskriftene som gjelder for virksomheten. Sammen med deltakerne ser vi på hvordan kravene påvirker deres hverdag, og hvordan de kan finne frem i regelverket for å få oversikt over hvilke bestemmelser som gjelder for bedriften.
Våre kurs
 Trygg mat-kultur
Trygg mat-kultur
Hva er egentlig Food Safety Culture?
Det stilles stadig strengere krav gjennom mattrygghetsstandarder. Få tips til hvordan du kan få med hele virksomheten mot felles mål.
Les mer
 Allergener og allergenhåndtering
Allergener og allergenhåndtering
Matvareallergier har blitt en stor helserisiko
Få en introduksjon om temaet allergener og hvorfor det er viktig å ha kontroll med allergener i produksjonsmiljø, storkjøkken og frembud av mat.
Les mer
 Analyseresultater, tolkning og trending
Analyseresultater, tolkning og trending
Få mer kunnskap om analysesertifikatet du mottar etter analyser
Mange opplever at analysesertifikatet er bare "bokstaver og tegn" - lær å tolke det.
Les mer
 Beredskapstrening
Beredskapstrening
Hva gjør man når uhellet er ute?
Lær om viktigheten av å trene på beredskap, sette opp et beredskapsteam, gjennomføre sporbarhetstester og få tips til hvordan man kan trene på beredskap i egen bedrift.
Les mer
 BRC - BRCGS Food Safety Versjon 9
BRC - BRCGS Food Safety Versjon 9
Ny standard betyr nye krav og oppdateringer
Få en introduksjon til standardens sentrale krav og tips til hvordan kravene kan løses i versjon 9 av BRCGS Food Safety.
Les mer
 E. coli
E. coli
Er alle E. coli-bakterier farlige?
Bli bedre kjent med den sykdomsframkallende bakterien E. coli som kan føre til helsefare i Norge.
Les mer
 Fett og oljer
Fett og oljer
Ett fett?
Lær om kjemien bak fett og oljer, og få en kort kjemisk forståelse av disse.
Les mer
 Food Fraud & Food Defence
Food Fraud & Food Defence
Hva er matsvindel og hvordan påvirker det oss?
Vi setter søkelyset på det viktige arbeidet med å opprette og utføre forebygging av matsvindel, og food defence.
Les mer
 FSSC 22000
FSSC 22000
Hvordan holde liv i, og forenkle systemene rundt sertifisering?
Vi belyser viktige krav og gir eksempler på løsninger. Kurset egner seg godt for kvalitetsledere og medlemmer av HACCP-grupper.
Les mer
 Grunnforutsetninger og risikofaktorer
Grunnforutsetninger og risikofaktorer
Hvorfor må man ha kjennskap til mulige risikofaktorer?
Få en dypere forståelse av risikofaktorene som er nødvendig å kjenne til før man utfører HACCP-analyse.
Les mer
 HACCP
HACCP
Todagers kurs med systematisk risikostyring for trygg mat
Lær å bruke HACCP som verktøy for å identifisere og ha kontroll over bedriftens farer.
Les mer
 Holdbarhet (kjemisk, mikrobiologisk og sensorisk)
Holdbarhet (kjemisk, mikrobiologisk og sensorisk)
Hvordan finner man produktets holdbarhet?
Få en introduksjon til de ulike faktorene som påvirker holdbarhetstiden - kjemi, mikrobiologi og sensorikk - og muligheten til å stille oppfølgingsspørsmål direkte til våre fagpersoner.
Les mer
 Ledelse av leverandørrevisjoner
Ledelse av leverandørrevisjoner
Gjør revisjonene mer profesjonelle
Lær hvordan sette opp et godt revisjonsprogram med metodikk for utvelgelse.
Les mer
 Matkontaktmaterialer og samsvarserklæringer
Matkontaktmaterialer og samsvarserklæringer
For alle som produserer eller importerer emballasje for næringsmiddelprodusenter
Få en grundig introduksjon til det generelle regelverket knyttet til matkontaktmaterialer og kravene til samsvarserklæringer.
Les mer
Mikrobiologi for kvalitetsavdelingen
Mikrobiologi for kvalitetsavdelingen
Bli kjent med mikrobiologiske farer
Få større forståelse for generell mikrobiologi og kunnskap om tolkning av mikrobiologiske analyser.
Les mer
 PFAS
PFAS
Hvordan påvirker de nye grenseverdiene deg som produserer næringsmidler?
Næringsmidler kan være kilde til PFAS. Lær om gjeldende grenseverdier og hva det betyr i praksis.
Les mer
 Salmonella - en tøff liten rakker
Salmonella - en tøff liten rakker
Hvor kommer smitte med Salmonella fra?
Bli bedre kjent med en av de patogene bakteriene som kan føre til helsefare i Norge.
Les mer
 Grunnleggende sensorikk
Grunnleggende sensorikk
Grunnsmakstesting - bli kjent med egen tunge og de ulike grunnsmakene
Lær å bruke våre medfødte sanser; syn, lukt, smak og hørsel til sensorisk vurdering av næringsmiddel.
Les mer
Sporedannende bakterier i mat
Sporedannende bakterier i mat
De overlever det meste og er tøffere enn de fleste
Få mer kunnskap om de vanligste sporedannende bakeriene Bacillus og Clostridium.
Les mer
 Uønskede stoffer
Uønskede stoffer
Uønskede organiske og uorganiske stoffer
Hvor skadelig er MOSH og MOAH egentlig? Og hvordan blir produkter eksponert for kontamineringsrisiko med disse stoffene?
Les mer
 Praktisk årsaksanalyse i avviksbehandling
Praktisk årsaksanalyse i avviksbehandling
Effektiv håndtering for å finne årsak og forhindre gjentakelse
Få nyttige tips og gode verktøy som gjør det enklere å etterleve krav om årsaksanalyse.
Les mer
E-læring
Et bredt spekter av digitale kurs utviklet for alle som jobber med produksjon, håndtering og kontroll av næringsmidler. Våre e-læringskurs gir fleksibel opplæring av høy faglig kvalitet, og er tilpasset både nyansatte, erfarne medarbeidere og ledere som ønsker å styrke sin kompetanse innen mattrygghet.




